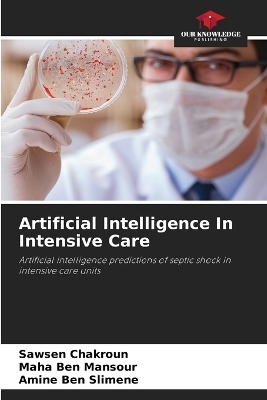
Artificial Intelligence In Intensive Care

Optimizing the Performance of High-Speed Pharmaceutical Packaging Lines. DE
Buch | Softcover
2025
|
Our Knowledge Publishing
ISBN: 9783838144931
CHF 118,85 (inkl. MwSt)
- Titel nicht im Sortiment